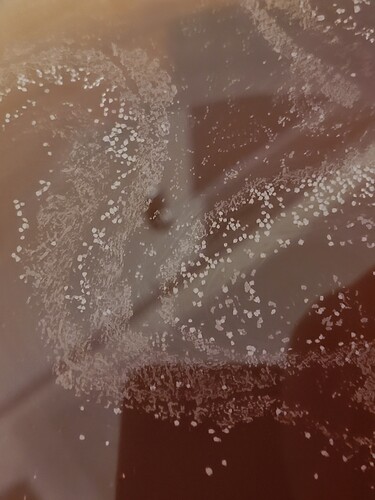

Hello fellow brewers, I have just completed 2 weeks in secondary for a psudo lager with omega lutra. When I opened the bucket I was surprised to find a slightly oily look on the top with small white patches that are definitely not bubbles. Wondering if anyone else has had this with luta or if I have an infection?
I just pulled the last pint of a beer I used Lutra yeast in. It did not look like that, it looked pretty much like most other beers when I kegged. Lutra does look different from other dry beer yeast in the packet though.
I would take a sample, smell, taste it and get a gravity reading. Some infections might drive the gravity reading to unusually low reading for beer.
If it is a pellicle infection you might be able to scoop it off the top.
Good luck. This kind of stuff can be frustrating.
Yeah, I pulled an oz or so off before I opened the bucket, and it tasted okay. I was surprised to see this. Honestly, only moved to secondary to get it off the yeast cake, and let it sit to clear while I polished off one of my kegs.
I did notice that the package of lutra was puffed up when I got it, and it smelled a bit sulfur like. It was my first time using a slurry so I didn’t think too much of it, but I wonder if the yeast was bad?
Either way I just got the fixings for another brew day, and still have half a keg so I’ll be okay.
id go ahead and keg it. If you suspect infection Id be leary of bottling it
At this point i am going to let it sit for another week to see if it grows. I am moving to our first house in a week, so no rush on this beer and i have already ordered thr kit again, with lutra dry this time. Figure infection happen to everyone from time to time, and i am fairly Anal with sanitation.
Is there anything to be concerned with when adding potentially infected beer into a keg? Is it fairly easy to kick the infection with proper keg cleaning, or would this equipment be best for future sours?
Iv had a lacto infection in some kegs nothing a little bleach didn’t cure. Not sure thats what you have. Taste it? You could bottle and just drink them